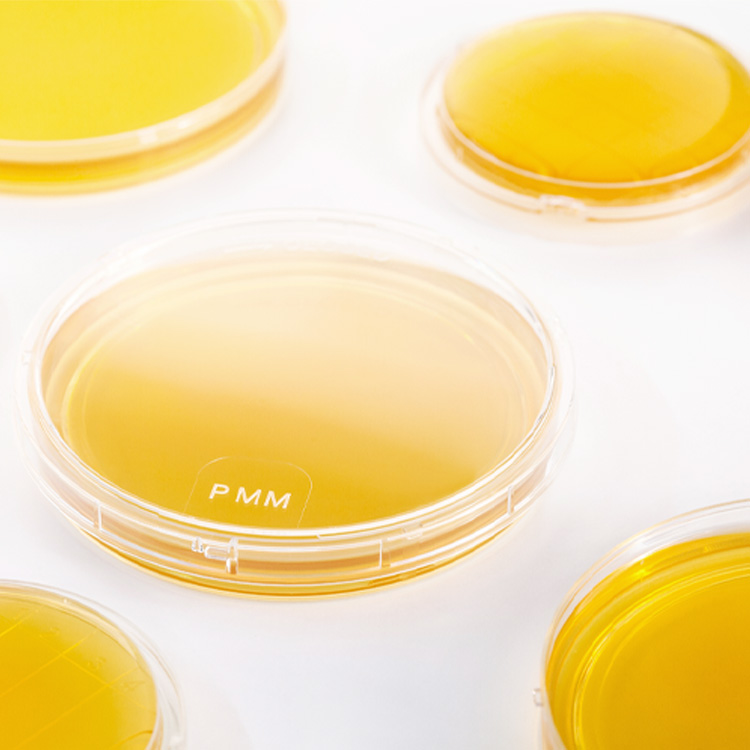

PMM – производитель готовых питательных сред для фармацевтических лабораторий и производств.
Компания была основана в январе 2013 года доктором Ролфом Мюллером, который более 40 лет назад создал компанию Heipha Dr. Müller GmbH.
![]() | Продукция PMM для фармацевтических лабораторий и производств:
|
![]() | ![]() | ![]() | ![]() | ![]() |
![]() | Соответствие требованиямПроизводство осуществляется в чистых помещениях в соответствии с EC-GMP, ISO 14644 и предписаниями FDA для стерильных препаратов, производимых в асептических условиях.Компания сертифицирована согласно ISO 9001:2015 в ноябре 2015 г. |
![]() | HLR – эксклюзивный дистрибьютор готовых питательных сред PMM в УкраинеМы тесно сотрудничаем со специалистами PMM и обеспечиваем:
|
На складе HLR постоянно поддерживается запас наиболее востребованных позиций.